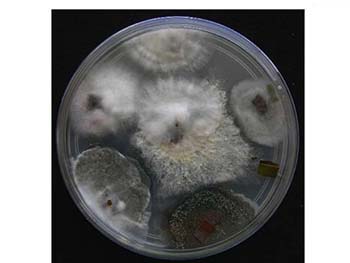

vol. 5, No. 3, 2013, p. 326-513
Procedimentos de Submissão para Open Access
Os manuscritos submetidos na Revista Virtual de Química (RVq) adotam a implementação total do sistema open access, onde os autores contribuem com parte dos custos da Publicação de seus artigos. Ver mais...
A Mata Atlântica e o Projeto I-FLORA
Bárbara Vasconcellos da Silva, Lidilhone Hamerski, Michelle Jakeline Cunha Rezende
http://dx.doi.org/10.5935/1984-6835.20130031
Biotecnologia da Biodiversidade: Um Novo Instituto Brasileiro
Antonio Paes de Carvalho, Paulo Cavalcanti Gomes Ferreira

http://dx.doi.org/10.5935/1984-6835.20130032
Substâncias de Origem Vegetal com Atividade Larvicida Contra Aedes aegypti
Walmir S. Garcez, Fernanda R. Garcez, Lilliam M. G. E. da Silva, Ulana C. Sarmento

http://dx.doi.org/10.5935/1984-6835.20130034
Usando as Cores da Natureza para Atender aos Desejos do Consumidor: Substâncias Naturais como Corantes na Indústria Alimentícia
Lidilhone Hamerski, Michelle J. C. Rezende, Bárbara V. Silva

http://dx.doi.org/10.5935/1984-6835.20130035
Fungos Endofíticos: Uma Fonte Inexplorada e Sustentável de Novos e Bioativos Produtos Naturais
Vanessa M. Chapla, Carolina R. Biasetto, Angela R. Araujo
http://dx.doi.org/10.5935/1984-6835.20130036
Consolidaçao dos Grupos de Pesquisa em Plantas Medicinais e Fitoterápicos no Brasil
Paula G. Santos, Antonio C. Siani

http://dx.doi.org/10.5935/1984-6835.20130037
Editoria da RVq - Editoria da RVq - PubliSBQ
Instituto de Química, Universidade Federal Fluminense,
Campus do Valonguinho, 24020-141, Centro, Niterói-RJ, Brasil
E-mail: rvq@sbq.org.br


